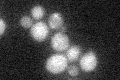
YMR049C
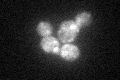
YMR049C
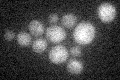
YMR049C

View description
Constituent of 66S pre-ribosomal particles, forms a complex with Nop7p and Ytm1p that is required for maturation of the large ribosomal subunit; required for maturation of the 25S and 5.8S ribosomal RNAs; homologous to mammalian Bop1
Localization:
Intensity:
Fold change:
Significance:
-
C’ GFP library in SD
cytosol22.6 -
N' NOP1pr-GFP in SD

nucleolus124.97 -
N' TEF2pr-mCherry in SD

nucleus,nucleolus44.0215 -
N' NATIVEpr-GFP in SD

nuclear periphery78.3698 -
N' TEF2pr-VC and Cyto-VN in SD

nucleolus,nuclear periphery43.9645 -
C’ GFP library in SD+DTT

cytosol19.740.87No -
C’ GFP library in SD+H2O2
cytosol24.281.07No -
C’ GFP library in Starvation Media
cytosol19.740.87No -
C’ GFP library on the background of Pup2-DaMP

cytosol -
C’ GFP library on the background of CCT mutant

cytosol24.11281.06682No
